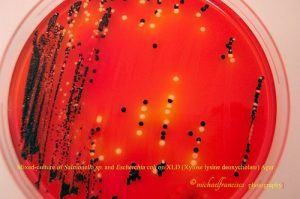
Fig: Mixed culture of E coli and Salmonella in XLD agar - Fig: Mixed culture ofE coliandSalmonellain XLD agar
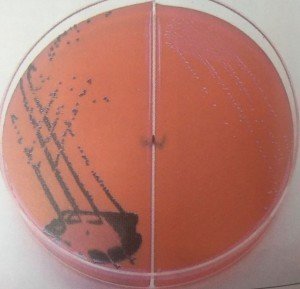
XLD Cultures: Left: Red-pink black centered colonies of Salmonella typhimurium  Right: Red-pink Shigella colonies - XLD Cultures:Left: Red-pink black centered colonies of Salmonella typhimuriumRight: Red-pink Shigella colonies

Xylose lysine deoxycholate (XLD) agar is a selective and differential medium for the isolation, cultivation, and differentiation of gram-negative enteric microorganisms. This media primarily isolates and differentiates Salmonella and Shigella from clinical and non-clinical specimens.
XLD agar selectively promotes the growth of Salmonellaand Shigellaby inhibiting other enteric pathogens and differentiates Gram-negative enteric bacteria based on xylose fermentation, lysine decarboxylation, and the production of hydrogen sulfide from the sodium thiosulphate.
XLD medium was formulated by Taylor for the isolation and differentiation of enteric pathogens.
Composition of XLDAgar
The key ingredients of XLD agar are three sugars (xylose, lactose,and sucrose), lysine, and ferric ammonium citrate.
| Ingredients | Amount (Gram/Liter) |
|---|---|
| Lactose | 7.5 gm |
| Sucrose | 7.5 gm |
| Sodium thiosulfate | 6.8 gm |
| L-Lysine | 5.0 gm |
| Sodium chloride | 5.0 gm |
| Xylose | 3.75 gm |
| Yeast extract | 3.0 gm |
| Sodium deoxycholate | 2.5 gm |
| Ferric ammonium citrate | 0.8 gm |
| Phenol red | 0.08 gm |
| Agar | 15.0 gm |
Yeast extract provides sources of nitrogen, carbon, and vitamins required for organism growth. Sodium deoxycholate present in the medium inhibits the growth of Gram-positive organisms. Sodium chloride maintains the osmotic balance, and agar is the solidifying agent.
Ingredients in Per liter formulations:
Principle of XLDAgar
Xylose is rapidly fermented by most Gram-negative enteric bacteria, including Salmonella. This causes acidification of the medium, turning the phenol red indicator yellow. Since Shigellaspp doesn’t utilize xylose, acidification does not occur, and red colonies are produced. This property aids in the differentiation of Shigella spp.
After the xylose supply is exhausted, Salmonellaspp decarboxylates lysine, increasing the pH to alkaline condition, and also produces red colonies like Shigella spp. However, Salmonellae also metabolize thiosulfate to produce hydrogen sulfide, which leads to the formation of colonies with black centers and allows them to be differentiated from the similarly colored Shigellacolonies.
Organisms that ferment lactose, sucrose, and xylose but are lysine decarboxylase negative cause an acid pH and produce yellow colonies.
Preparation of Media
- Suspend 55 gm of the medium in one liter of purified water.
- Heat with frequent agitation until the medium reaches the boiling point.
- Avoid overheating. Do not autoclave.
- Transfer immediately to a water bath at 50°C.
- After cooling, pour into sterile Petri plates.
It is advisable not to prepare large volumes that will require prolonged heating, thereby producing precipitate.
Result Interpretation
After incubation of the plates with test organisms, various colored colonies develop, and differentiation is based on it.
| Colony characteristics on XLD Agar | Basis of reaction | Possible pathogens |
|---|---|---|
| Red colonies | Alkaline reaction, non-fermentation of xylose/lactose/sucrose or fermentation of xylose followed by decarboxylation of lysine | Shigella spp, Providencia spp, Pseudomonas spp, and H2S non-producing Salmonella spp |
| Red colonies with a black center | Xylose positive, lysine decarboxylase positive, capable of producing H2S, thus black centered colonies in alkaline pH | H2S producing Salmonella spp S. Typhi S. Typhimurium |
| Yellow opaque colonies | Ferment xylose but not lactose and sucrose, lysine negative, gives acid pH | E.coli, Klebsiella/Enterobacter Citrobacter, Serratia and Proteus spp |
| Yellow colonies | Lactose or sucrose fermentation, lysine negative, gives acid pH | Possible coliforms Sucrose positive Proteus spp |
Quality Control
| Organism | Growth and colony morphology |
|---|---|
| S.typhimurium ATCC 14028 | Good growth, Red colonies with a black center |
| S.flexneri ATCC 12022 | Luxuriant growth, red colonies |
| Escherichia coli ATCC 25922 | Partially inhibited, Large, flat, yellow colonies |
| Enterococcus faecalis ATCC 29212 | Partial to complete inhibition, clear pinpoint colonies |
The commercially available dehydrated media should be homogeneous, free-flowing, and light pink-beige in color. After preparation, the medium is bright red to reddish-orange, trace to slightly with neutral pH (7.20-7.60).
Quality testing of the prepared media plates should be done by performing sterility and performance testing.
- Sterility testing: Incubate un-inoculated plates of XLD agar for 48 hours at 35-37°C and observe any growth. After 48 hours, the sterility test plate should remain clear. Discard the whole lot if any colonies are seen.
- Performance testing: Inoculate known standard strains on XLD agar plates, incubate for 18- 24 hours at 35-37°C, and observe for growth and colony characteristics.
Uses of XLD Agar
- For isolation and differentiation of Salmonellaand Shigellaspp from other enteric pathogens.
- Isolation and screening of samples containing mixed flora suspected of harboring enteric pathogens, e.g., medical specimens or food products.
- Detection of Salmonella in non-sterile pharmaceutical products (in accordance with EP, USP) and food, water dairy products, etc.

Limitations
- A single medium may not be enough to recover all pathogens, so a less selective medium such as MacConkey agar should also be used.
- Non-enteric pathogens such as Pseudomonasmay grow in the medium producing red colonies like Shigella; therefore, further, identification is necessary.
- Proteus mirabilismay produce small black-centered colonies similar to Salmonella but can be distinguished from Salmonella colonies, the latter being large, with a big black center.
- Prolonged incubation (more than 48 hours) may lead to false-positive results.
- Salmonella Paratyphi, S. Choleraesius, S.Pullorum and S.Gallinarum produce red colonies without a black center, hence may appear like Shigella.
- Since it is a selective medium, further subculture onto a basal medium is essential before performing biochemical tests, serotyping, etc.
References
- Bailey & Scott’s Diagnostic Microbiology, Forbes, 11th edition
- Review of Medical Microbiology and Immunology, Lange Medical Books, 13th edition
- Koneman’s Color Atlas and Textbook of Diagnostic Microbiology (Color Atlas & Textbook of Diagnostic Microbiology), 7th edition